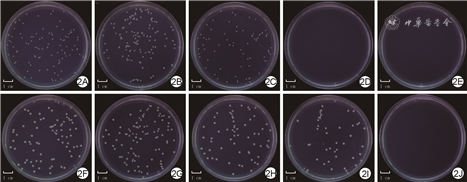

研究活性氧响应性抗菌微针对糖尿病小鼠细菌定植全层皮肤缺损创面的影响。
采用实验研究方法。合成活性氧响应性交联剂N1-(4-溴苄基)-N3-(4-溴苯基)-N1,N1,N3,N3-四甲基丙烷-1,3-二胺(TSPBA),混合相应成分制成聚乙烯醇-TSPBA(PVA-TSPBA)微针、PVA-ε-聚赖氨酸(ε-PL)-TSPBA微针、PVA-TSPBA-透明质酸钠(SH)微针、PVA-ε-PL-TSPBA-SH微针。将PVA-TSPBA微针分别置于单纯磷酸盐缓冲液(PBS)和含过氧化氢的PBS中,观察浸泡0(即刻)、3、7、10 d微针降解情况,表示其活性氧响应性。将用含过氧化氢的LB培养基培养的金黄色葡萄球菌标准菌株与大肠埃希菌标准菌株各自按随机数字表法(分组方法下同)分为空白对照组(不行任何处理,下同)以及与含相应浓度ε-PL的PVA-ε-PL-TSPBA微针共培养的0 g/L ε-PL组、1.0 g/L ε-PL组、5.0 g/L ε-PL组、10.0 g/L ε-PL组,培养24 h,观察细菌生长情况并计算细菌相对存活率(样本数为3)。将对数生长期的小鼠成纤维细胞系3T3细胞(生长周期下同)分为空白对照组以及用含相应浓度ε-PL的PVA-ε-PL-TSPBA微针浸提液培养的0 g/L ε-PL组、1.0 g/L ε-PL组、5.0 g/L ε-PL组、10.0 g/L ε-PL组,培养24 h,用光学显微镜观察细胞生长情况,用细胞计数试剂盒8(CCK-8)法检测并计算细胞相对存活率(以此表示细胞毒性,样本数为6)。取PVA-TSPBA微针与PVA-TSPBA-SH微针,用光学显微镜观察2种微针形貌,用微机控制电子万能试验机检测2种微针机械性能(以临界力表示,样本数为6)。取6只6~8周龄雄性BALB/c小鼠(性别、鼠龄下同),分为PVA-TSPBA组与PVA-TSPBA-SH组(每组3只),用相应微针垂直按压背部皮肤1 min后,观察按压完成后0、10、20 min皮肤情况。另取3T3细胞,分为空白对照组,用含相应浓度ε-PL的PVA-ε-PL-TSPBA微针浸提液培养的0 g/L ε-PL组、单纯5.0 g/L ε-PL组,用含5.0 g/L ε-PL的PVA-ε-PL-TSPBA-SH微针浸提液培养的5.0 g/L ε-PL+SH组,CCK-8法检测并计算培养24、48、72 h细胞相对存活率,以此表示细胞增殖活性(样本数为6)。取18只BALB/c小鼠,通过高糖高脂饮食联合链脲佐菌素注射诱导为糖尿病小鼠模型后,分为无菌敷贴组、0 g/L ε-PL+SH组与5.0 g/L ε-PL+SH组(每组6只),在每只小鼠背部制作全层皮肤缺损创面后滴加金黄色葡萄球菌溶液,制成糖尿病小鼠细菌定植全层皮肤缺损创面模型,0 g/L ε-PL+SH组、5.0 g/L ε-PL+SH组小鼠创面覆盖含相应浓度ε-PL的PVA-ε-PL-TSPBA-SH微针后,3组小鼠创面均外覆无菌手术敷贴。于伤后0、3、7、12 d观察创面愈合情况,计算伤后3、7、12 d创面愈合率;伤后12 d,取创面及创缘皮肤组织行苏木精-伊红染色,观察新生上皮生长及炎症细胞浸润情况。对数据行单因素方差分析、重复测量方差分析、Mann-Whitney U检验、Bonferroni法。
随着浸泡时间的延长,置于含过氧化氢PBS中的PVA-TSPBA微针逐渐溶解并于浸泡10 d完全降解,置于单纯PBS中的PVA-TSPBA微针仅发生溶胀而未溶解。培养24 h,5.0 g/L ε-PL组、10.0 g/L ε-PL组金黄色葡萄球菌未见生长,10.0 g/L ε-PL组大肠埃希菌未见生长;1.0 g/L ε-PL组、5.0 g/L ε-PL组、10.0 g/L ε-PL组金黄色葡萄球菌相对存活率较空白对照组明显降低(P<0.05或P<0.01),5.0 g/L ε-PL组、10.0 g/L ε-PL组大肠埃希菌相对存活率较空白对照组明显降低(P<0.01)。培养24 h,空白对照组、0 g/L ε-PL组、1.0 g/L ε-PL组、5.0 g/L ε-PL组、10.0 g/L ε-PL组细胞生长状态良好,组间细胞相对存活率相近(P>0.05)。PVA-TSPBA微针与PVA-TSPBA-SH微针的针体均呈四棱锥形,排列整齐,其中PVA-TSPBA-SH微针的针体更立体、棱角更分明。PVA-TSPBA-SH微针的临界力明显高于PVA-TSPBA微针(Z=3.317,P<0.01)。PVA-TSPBA-SH组小鼠按压完成后0 min微针穿透皮肤,10 min后针孔部分消失,20 min后针孔完全消失;PVA-TSPBA组微针未能穿透小鼠皮肤。培养24、48、72 h,5.0 g/L ε-PL+SH组细胞增殖活性均明显高于空白对照组(P<0.05或P<0.01)。无菌敷贴组小鼠创面愈合速度缓慢,渗出较多;0 g/L ε-PL+SH组小鼠创面愈合速度前期与无菌敷贴组相近,后期较无菌敷贴组加快,渗出中等;5.0 g/L ε-PL+SH组小鼠创面愈合较另2组快,渗出不多。5.0 g/L ε-PL+SH组小鼠伤后3、7、12 d创面愈合率分别为(40.6±4.2)%、(64.3±4.1)%、(95.8±2.4)%,明显高于无菌敷贴组的(20.4±2.7)%、(38.9±2.2)%、(59.1±6.2)%与0 g/L ε-PL+SH组的(21.6±2.6)%、(44.0±1.7)%、(82.2±5.3)%(P<0.01);0 g/L ε-PL+SH组小鼠伤后7、12 d创面愈合率明显高于无菌敷贴组(P<0.05或P<0.01)。伤后12 d,5.0 g/L ε-PL+SH组小鼠创面几乎完全上皮化且炎症细胞浸润较少,0 g/L ε-PL+SH组小鼠创面部分上皮化且伴大量炎症细胞浸润,无菌敷贴组小鼠创面未见明显上皮化且伴大量炎症细胞浸润。
基于TSPBA、聚乙烯醇、ε-PL及SH制备的复合微针可顺利刺穿小鼠皮肤并能通过缓慢响应创面中的活性氧从而溶解释放抗菌物质,抑制创面细菌定植,促进糖尿病小鼠细菌定植全层皮肤缺损创面修复。

随着人们生活方式的改变及人口老龄化加速,糖尿病的发病率也逐年升高,其中难愈性创面是糖尿病的主要并发症之一。糖尿病致慢性创面的高糖微环境不仅更容易引发细菌定植[1, 2],而且会诱导细胞分泌大量活性氧[3, 4, 5]。随之,过量的活性氧会阻碍创面的正常修复[6],且高水平的氧化应激会进一步刺激创面发生持续的炎症反应[7],从而形成慢性难愈合创面[8, 9]。据文献报道,约80%的慢性创面伴有细菌生物膜的形成,这可能也是导致创面修复缓慢甚至难以修复的原因之一[10]。此外,如何排除慢性创面上坏死组织对传统敷料渗透创面的影响也是临床医师在治疗过程中面对的另一个挑战。因此,穿透创面坏死组织及细菌生物膜来有效清除慢性创面微环境中过量的活性氧是促进创面愈合的关键。微针贴片是一种安全、高效、无痛的新型经皮给药制剂[11, 12, 13, 14],近年来受到人们的广泛关注。本研究拟设计一种具有良好的机械性能且兼具抗菌作用和清除创面活性氧作用的可溶性微针,并将其应用于糖尿病小鼠细菌定植全层皮肤缺损创面,探究其对创面修复的影响。
本研究遵循国家以及陆军军医大学(第三军医大学)动物实验伦理委员会关于实验动物管理和使用的相关规定。
健康无特殊病原体级6~8周龄雄性BALB/c小鼠28只(体重约20 g)购自陆军军医大学(第三军医大学)实验动物中心,许可证号:SCXK(渝)20170002。小鼠Fb系3T3细胞株、金黄色葡萄球菌ATCC 6538、大肠埃希菌ATCC 25922购自美国模式培养物集存库。聚乙烯醇(1799型)、ε-聚赖氨酸(ε-PL)、4-(溴甲基)苯硼酸、N,N,N',N'-四甲基-1,3-丙二胺(TMPA)、氯化钠购自上海阿拉丁生化科技股份有限公司,即用型N,N-二甲基甲酰胺(DMF)、即用型四氢呋喃购自上海麦克林生化科技有限公司,链脲佐菌素(STZ)购自美国Sigma-Aldrich公司,透明质酸钠(SH)购自华熙生物科技股份有限公司,胰蛋白胨、酵母提取物购自美国Thermo Fisher Scientific公司,琼脂购自德国Biofroxx公司,DMEM高糖培养基、青霉素、链霉素、胎牛血清、PBS购自美国HyClone公司,细胞计数试剂盒8(CCK-8)细胞增殖及细胞毒性检测试剂盒购自美国GEN-VIEW公司,过氧化氢消毒液购自山东利尔康医疗科技股份有限公司,HE染色试剂盒购自北京索莱宝科技有限公司。20×20阵列的聚二甲基硅氧烷(PDMS)微针模具(微针单元形状为四棱锥形,其底部边长为300 μm、高度为600 μm,相邻微针的针尖间距为550 μm)购自台州微芯片医疗科技有限公司,无菌透明手术敷贴购自美国3M公司,TDL-5A型低速水平离心机购自常州金坛良友仪器有限公司,CX23型光学显微镜购自日本Olympus公司,尼康D5600相机购自日本尼康株式会社,HH•BII-Ⅱ型电热恒温培养箱购自上海跃进医疗器械有限公司,二氧化碳培养箱、M2e型多波长酶标仪购自美国Molecular Devices公司,微机控制电子万能试验机购自深圳美特斯工业系统有限公司。
根据文献[15]合成活性氧响应性交联剂N1-(4-溴苄基)-N3-(4-溴苯基)-N1,N1,N3,N3-四甲基丙烷-1,3-二胺(TSPBA):将4.6 mmol/L 4-(溴甲基)苯硼酸(1 g)和1.5 mmol/L TMPA(0.2 g)溶于40 mL DMF中,将溶液在60 ℃下搅拌24 h后,将混合物倒入100 mL四氢呋喃中过滤,并用四氢呋喃洗涤3次。将产物冷冻干燥过夜,获得纯TSPBA约0.6 g,后续用纯水配制成需要浓度。
活性氧响应性微针——聚乙烯醇-TSPBA(PVA-TSPBA)微针的制备:将35 g/L聚乙烯醇(450 μL)与35 g/L TSPBA(150 μL)混合(浓度、体积下同)。将0.5 mL混合液移至PDMS微针模具中,将模具放入自制的50 mL离心管(离心管下层填塞有已变成固体的胶水,模具放在固体胶水上方)中,于室温下以2 810×g离心20 min,使溶液完全填满模具的针尖部分。室温放置适当时间后,将适量剩余混合液填充至模具中。多次填充,至混合液填充完毕,待完全干燥后,将微针贴片从模具中剥离,于室温下干燥储存。
活性氧响应性抗菌微针——PVA-ε-PL-TSPBA微针的制备:将聚乙烯醇分别与实验需用浓度(本研究中采用1.0、5.0、10.0 g/L)ε-PL(400 μL)搅拌混匀后,逐滴加入TSPBA混合,后续操作同PVA-TSPBA微针的制备,制成含相应浓度ε-PL的PVA-ε-PL-TSPBA微针。
活性氧响应性机械性能加强微针——PVA-TSPBA-SH微针的制备:同PVA-TSPBA微针的制备操作至填充完毕,将30 g/L SH(0.5 mL)填入模具,室温干燥过夜,同前取出微针贴片保存。
活性氧响应性抗菌且机械性能加强微针——PVA-ε-PL-TSPBA-SH微针的制备:按照PVA-ε-PL-TSPBA微针的制备操作至填充完毕,后续操作同PVA-TSPBA-SH微针的制备。
所有微针在用于后续实验前均通过紫外照射灭菌处理。
将各1/4片PVA-TSPBA微针分别置于单纯PBS和含终物质的量浓度0.25 mmol/L过氧化氢的PBS中,观察浸泡0(即刻)、3、7、10 d微针的降解情况,以此表示其活性氧响应性,并用相机拍照记录。
用10 g/L胰蛋白胨、5 g/L酵母提取物、10 g/L氯化钠、15 g/L琼脂及纯水配制LB固体培养基,置于高压灭菌锅中灭菌20 min,稍冷却后倒入细菌培养皿中备用。
用10 g/L胰蛋白胨、5 g/L酵母提取物、10 g/L氯化钠及纯水配制LB液体培养基,加入终物质的量浓度0.25 mmol/L过氧化氢,分别加入终菌液浓度1×106 CFU/mL的金黄色葡萄球菌、大肠埃希菌,加入48孔板,每孔200 µL。将2种细菌按随机数字表法(分组方法下同)各自分为空白对照组(不行任何处理,下同)、0 g/L ε-PL组、1.0 g/L ε-PL组、5.0 g/L ε-PL组、10.0 g/L ε-PL组,每组3孔。后4组细菌LB液体培养基中分别加入1片含相应浓度ε-PL的PVA-ε-PL-TSPBA微针,于37 ℃电热恒温培养箱(培养条件下同)中共培养4 h后,各孔补充800 µL LB液体培养基,继续共培养20 h。各孔取100 µL稀释的细菌悬液(1×102 CFU/mL)涂覆在LB固体培养基上,培养24 h。相机拍照观察各组细菌生长情况,计算各组细菌的相对存活率。细菌相对存活率=各组菌落数÷空白对照组菌落数×100%。
分别取含0、1.0、5.0、10.0 g/L ε-PL的PVA-ε-PL-TSPBA微针各1片,浸泡于含体积分数10%胎牛血清、100万U/mL青霉素、100 µg/mL链霉素的DMEM高糖培养基(下称完全培养基)中24 h,制备各种微针浸提液备用。
取对数生长期的3T3细胞,调整细胞浓度为1×105个/mL,接种至96孔板中,每孔200 µL。将细胞分为空白对照组、0 g/L ε-PL组、1.0 g/L ε-PL组、5.0 g/L ε-PL组、10.0 g/L ε-PL组,每组6孔,用完全培养基于37 ℃、含体积分数5%二氧化碳培养箱中培养(即常规培养)24 h,吸弃孔内培养基,空白对照组更换新的完全培养基,后4组加入200 µL含相应浓度ε-PL的微针浸提液培养(另设不含细胞的阴性对照)。培养24 h,于200倍光学显微镜下观察各组细胞形态。同时向每孔加入20 µL CCK-8溶液,继续常规培养2~3 h,用多波长酶标仪测定每孔细胞在450 nm处的吸光度值。计算细胞相对存活率,以此表示细胞毒性,细胞相对存活率=(各ε-PL组吸光度值-阴性对照吸光度值)÷(空白对照组吸光度值-阴性对照吸光度值)×100%。
取PVA-TSPBA微针与PVA-TSPBA-SH微针各1片,将微针针尖向上固定在玻片上,于200倍光学显微镜下观察微针形貌。
取PVA-TSPBA微针与PVA-TSPBA-SH微针各1片,将微针针尖向上,置于微机控制电子万能试验机下层的金属平板上。上方的金属探头以0.5 mm/min的速度向下运行,当探头接触到针尖后(触发力为50 mN),维持原速继续向下运行,直至针体发生100%(即600 μm)的形变,记录此时的临界力(以此表示其机械性能)。本实验重复6次。
取6只BALB/c小鼠,分为PVA-TSPBA组与PVA-TSPBA-SH组,每组3只。每只小鼠以50 mg/kg腹腔注射10 g/L戊巴比妥钠麻醉后常规背部脱毛,将小鼠背部皮肤提起,将1片微针(每组用相应微针)垂直按压在皮肤上停留1 min后取下,观察按压完成后0、10、20 min皮肤情况并用相机拍照记录。
分别取含0、5.0 g/L ε-PL的PVA-ε-PL-TSPBA微针与含5.0 g/L ε-PL的PVA-ε-PL-TSPBA-SH微针各1片,浸泡于完全培养基中24 h,制备各种微针浸提液备用。
取对数生长期的3T3细胞,调整细胞浓度为2×104个/mL,接种至96孔板中,每孔200 µL。将细胞分为空白对照组、0 g/L ε-PL组、单纯5.0 g/L ε-PL组、5.0 g/L ε-PL+SH组,每组18孔。常规培养24 h后,吸弃孔内原培养基,空白对照组更换新的完全培养基,0 g/L ε-PL组、单纯5.0 g/L ε-PL组细胞分别加入200 µL含相应浓度ε-PL的PVA-ε-PL-TSPBA微针浸提液培养,5.0 g/L ε-PL+SH组细胞加入含5.0 g/L ε-PL的PVA-ε-PL-TSPBA-SH微针浸提液培养(另设不含细胞的阴性对照)。分别于培养24、48和72 h,每组取6孔细胞,向每孔加入20 µL CCK-8溶液,后续操作与计算同1.5.2,以细胞相对存活率表示细胞增殖活性。
参照文献[16]关于糖尿病鼠的建模方法,取22只BALB/c小鼠,予以高糖高脂饲料自由进食(实验期间维持饮食),于每天上午腹腔注射10 mg/mL STZ 50 mg/kg,连续注射5 d,建立糖尿病小鼠模型。注射完成1周后开始连续监测小鼠尾静脉血的血糖水平,将连续3 d血糖≥16.7 mmol/L的18只小鼠视为糖尿病模型造模成功,纳入后续研究。
将糖尿病小鼠分为无菌敷贴组、0 g/L ε-PL+SH组与5.0 g/L ε-PL+SH组,每组6只。每只小鼠以50 mg/kg腹腔注射10 g/L戊巴比妥钠麻醉,常规背部脱毛及碘伏消毒后在小鼠背部用打孔器制造直径6 mm的全层皮肤缺损创面。伤后立即在创面上滴加5 µL金黄色葡萄球菌溶液(1×108 CFU/mL)制备糖尿病细菌定植创面模型。随即,0 g/L ε-PL+SH组、5.0 g/L ε-PL+SH组小鼠创面覆盖剪裁成创面大小的含相应浓度 ε-PL的PVA-ε-PL-TSPBA-SH微针,之后均外覆无菌手术敷贴;无菌敷贴组创面仅用无菌手术敷贴覆盖。后续每次观察时更换各组无菌手术敷贴。
无菌敷贴组建模后即刻、另2组微针覆盖后即刻(统称伤后0 d)拍照记录创面情况,伤后3、7、12 d拍照记录各组小鼠创面愈合情况,采用Image J图像分析软件(美国国立卫生研究院)量化创面面积并计算创面愈合率,创面愈合率=(伤后0 d创面面积-伤后各时间点创面面积)÷伤后0 d创面面积×100%。伤后12 d,将小鼠同前麻醉,取创面及创缘周围2 mm的皮肤组织,40 g/L多聚甲醛固定、石蜡包埋、切片(厚度4 µm),行常规HE染色,于40倍光学显微镜下观察新生上皮生长及炎症细胞浸润情况。
采用SPSS 20.0统计软件进行数据分析。计量资料数据均符合正态分布,以表示,方差不齐时组间比较采用Mann-Whitney U检验;方差齐时单一时间点多组间总体比较行单因素方差分析,多个时间点多组间总体比较行重复测量方差分析,组间两两比较采用Bonferroni法(软件自动略去该统计量值)。P<0.05为差异有统计学意义。
随着浸泡时间的延长,置于单纯PBS中的PVA-TSPBA微针仅发生溶胀而未溶解,置于含过氧化氢PBS中的PVA-TSPBA微针逐渐溶解并于浸泡10 d完全降解。见图1。


培养24 h,5.0 g/L ε-PL组、10.0 g/L ε-PL组金黄色葡萄球菌未见生长。空白对照组、0 g/L ε-PL组、1.0 g/L ε-PL组、5.0 g/L ε-PL组、10.0 g/L ε-PL组金黄色葡萄球菌相对存活率分别为(100±7)%、(107±7)%、(81±4)%、0、0,组间总体比较,差异有统计学意义(F=247.320,P<0.001)。与空白对照组比较,0 g/L ε-PL组金黄色葡萄球菌相对存活率无明显变化(P>0.999),1.0 g/L ε-PL组、5.0 g/L ε-PL组、10.0 g/L ε-PL组金黄色葡萄球菌相对存活率明显降低(P=0.027、<0.001、<0.001)。见图2A, 2E。


注:各ε-聚赖氨酸(ε-PL)组细菌与含相应浓度ε-PL的聚乙烯醇-ε-PL-N1-(4-溴苄基)-N3-(4-溴苯基)-N1,N1,N3,N3-四甲基丙烷-1,3-二胺微针共培养
培养24 h,10.0 g/L ε-PL组大肠埃希菌未见生长。空白对照组、0 g/L ε-PL组、1.0 g/L ε-PL组、5.0 g/L ε-PL组、10.0 g/L ε-PL组大肠埃希菌的相对存活率分别为(100±6)%、(105±3)%、(89±6)%、(44±3)%、0,组间总体比较,差异有统计学意义(F=219.069,P<0.001)。与空白对照组比较,1.0 g/L ε-PL组及0 g/L ε-PL组大肠埃希菌相对存活率无明显变化(P=0.243、>0.999),5.0 g/L ε-PL组、10.0 g/L ε-PL组大肠埃希菌相对存活率明显降低(P<0.001)。见图2F2J。
培养24 h,各组细胞均正常增殖且生长状态良好,细胞排列有序,形态均一。见图3。培养24 h,空白对照组、0 g/L ε-PL组、1.0 g/L ε-PL组、5.0 g/L ε-PL组、10.0 g/L ε-PL组细胞相对存活率分别为(100.0±2.3)%、(100.6±3.3)%、(99.8±2.7)%、(101.1±2.1)%、(101.6±1.4)%,组间总体比较,差异无统计学意义(F=0.496,P=0.738)。


注:各ε-聚赖氨酸(ε-PL)组细胞用含相应浓度ε-PL的聚乙烯醇-ε-PL-N1-(4-溴苄基)-N3-(4-溴苯基)-N1,N1,N3,N3-四甲基丙烷-1,3-二胺微针浸提液培养
结合2.2结果,后续实验中选用5.0 g/L ε-PL。
PVA-TSPBA微针与PVA-TSPBA-SH微针的针体均呈四棱锥形,排列整齐,其中PVA-TSPBA-SH微针的针体更立体、棱角更分明。见图4。PVA-TSPBA-SH微针的临界力为(293.5±18.5)mN,明显高于PVA-TSPBA微针的(14.8±1.8)mN(Z=3.317,P=0.001)。


PVA-TSPBA-SH组小鼠按压完成后0 min微针穿透皮肤、针孔清晰可见,10 min 后部分皮肤恢复正常且针孔消失,20 min后针孔完全消失;而PVA-TSPBA组小鼠按压完成后各时间点微针均未能穿透皮肤,皮肤上未见明显针孔。见图5。


随着培养时间的延长,各组细胞相对存活率均明显升高。培养各时间点,与空白对照组比较,0 g/L ε-PL组、单纯5.0 g/L ε-PL组细胞相对存活率均无明显变化(P>0.05),5.0 g/L ε-PL+SH组细胞相对存活率均明显升高(P<0.05或P<0.01)。见表1。

4组小鼠成纤维细胞系3T3细胞培养各时间点相对存活率比较(%,)
4组小鼠成纤维细胞系3T3细胞培养各时间点相对存活率比较(%,)
| 组别 | 样本数 | 24 h | 48 h | 72 h |
|---|---|---|---|---|
| 空白对照组 | 6 | 100±11 | 130±17 | 204±14 |
| 0 g/L ε-PL组 | 6 | 134±17 | 135±15 | 216±14 |
| 单纯5.0 g/L ε-PL组 | 6 | 138±16 | 128±18 | 218±8 |
| 5.0 g/L ε-PL+SH组 | 6 | 140±14a | 155±14b | 239±12b |
注:0 g/L ε-聚赖氨酸(ε-PL)组、单纯5.0 g/L ε-PL组分别用含相应浓度ε-PL的聚乙烯醇-ε-PL-N1-(4-溴苄基)-N3-(4-溴苯基)-N1,N1,N3,N3-四甲基丙烷-1,3-二胺(PVA-ε-PL-TSPBA)微针浸提液培养,最后一组用含5.0 g/L ε-PL的PVA-ε-PL-TSPBA-透明质酸钠(SH)微针浸提液培养;处理因素主效应,F=183.357,P<0.001;时间因素主效应,F=235.311,P<0.001;两者交互作用,F=0.593,P=0.702;与空白对照组比较,aP<0.01,bP<0.05
伤后各时间点各组小鼠创面愈合情况见图6。无菌敷贴组小鼠创面愈合速度缓慢,渗出较多,伤后12 d仍有大部分创面未愈合;0 g/L ε-PL+SH组小鼠创面愈合速度前期与无菌敷贴组相近,后期较无菌敷贴组加快,渗出中等;与无菌敷贴组、0 g/L ε-PL+SH组比较,5.0 g/L ε-PL+SH组小鼠创面愈合较快,渗出不多。与无菌敷贴组比较,0 g/L ε-PL+SH组小鼠伤后7、12 d创面愈合率以及5.0 g/L ε-PL+SH组小鼠伤后3、7、12 d创面愈合率明显升高(P<0.05或P<0.01);与0 g/L ε-PL+SH组比较,5.0 g/L ε-PL+SH组小鼠伤后3、7、12 d创面愈合率明显升高(P<0.01)。见表2。伤后12 d,5.0 g/L ε-PL+SH组小鼠创面几乎完全上皮化且炎症细胞浸润较少,0 g/L ε-PL+SH组小鼠创面部分上皮化且伴大量炎症细胞浸润,无菌敷贴组小鼠创面未见明显上皮化区域且伴大量炎症细胞浸润。见图7。


注:0 g/L ε-聚赖氨酸(ε-PL)+透明质酸钠(SH)组、5.0 g/L ε-PL+SH组创面覆盖含相应浓度ε-PL的聚乙烯醇-ε-PL-N1-(4-溴苄基)-N3-(4-溴苯基)-N1,N1,N3,N3-四甲基丙烷-1,3-二胺-SH微针

3组糖尿病小鼠细菌定植全层皮肤缺损创面伤后各时间点愈合率比较(%,)
3组糖尿病小鼠细菌定植全层皮肤缺损创面伤后各时间点愈合率比较(%,)
| 组别 | 鼠数(只) | 伤后3 d | 伤后7 d | 伤后12 d |
|---|---|---|---|---|
| 无菌敷贴组 | 6 | 20.4±2.7 | 38.9±2.2 | 59.1±6.2 |
| 0 g/L ε-PL+SH组 | 6 | 21.6±2.6 | 44.0±1.7c | 82.2±5.3a |
| 5.0 g/L ε-PL+SH组 | 6 | 40.6±4.2ab | 64.3±4.1ab | 95.8±2.4ab |
注:0 g/L ε-聚赖氨酸(ε-PL)+透明质酸钠(SH)组、5.0 g/L ε-PL+SH组创面覆盖含相应浓度ε-PL的聚乙烯醇-ε-PL-N1-(4-溴苄基)-N3-(4-溴苯基)-N1,N1,N3,N3-四甲基丙烷-1,3-二胺-SH微针;处理因素主效应,F=711.051,P<0.001;时间因素主效应,F=717.622,P<0.001;两者交互作用,F=13.481,P<0.001;与无菌敷贴组比较,aP<0.01,cP<0.05;与0 g/L ε-PL+SH组比较,bP<0.01


注:黑色双向箭头示未上皮化区域;0 g/L ε-聚赖氨酸(ε-PL)+透明质酸钠(SH)组、5.0 g/L ε-PL+SH组创面覆盖含相应浓度ε-PL的聚乙烯醇-ε-PL-N1-(4-溴苄基)-N3-(4-溴苯基)-N1,N1,N3,N3-四甲基丙烷-1,3-二胺-SH微针
针对糖尿病致慢性创面,外科临床上最常用的方法是通过清创以去除创面的细菌生物膜及坏死感染组织。然而有文献报道,在清创2 d后,在创面上又观察到细菌生物膜生成[17],且清创会给患者带来疼痛引起不适。传统抗菌及促创面愈合的敷料、乳膏、凝胶等因创面细菌生物膜及坏死组织的存在,无法有效渗透至创面深处[18, 19]。迫切需要开发一种渗透性良好的药物输送系统,通过改善微环境来促进创面愈合[9]。微针贴片通过微针阵列实现透皮给药[11, 12,20],在创面上创造微米级的药物运输通道[20, 21],不仅能有效突破创面细菌生物膜及坏死组织屏障[14],打破这些生物屏障对药物的阻滞作用,提高药物对创面的渗透性,而且与传统的清创治疗方法相比,对患者造成的疼痛及损伤更小[22, 23, 24]。而在微针制备材料方面,聚乙烯醇是一种人工合成的水溶性高分子聚合物,具有良好的亲水性、化学稳定性和生物相容性[25, 26, 27]。有文献表明,聚乙烯醇可以与活性氧响应性交联剂形成水凝胶,这种水凝胶可以在含有活性氧的微环境下缓慢降解并持续释放所包裹的药物,从而实现药物控释的目的[15,28]。ε-PL是由赖氨酸残基连接而成的高分子聚合物,不但具有良好的水溶性和生物安全性,还具有广谱抗菌性,能够抑制大多数革兰阳性菌、革兰阴性菌、真菌及病毒等多种微生物,且抑菌能力强[29, 30]。因此,本研究团队结合微针能够有效穿透创面发挥药效及ε-PL广谱抗菌的优势,将活性氧响应性的水凝胶与ε-PL联合成功制备出了一种抗菌微针,以提高药物递送系统对创面的渗透力及抗菌性能。
本课题组利用PDMS微针模具制备了活性氧响应性微针,并通过实验验证了其活性氧响应性。处于正常愈合过程中的创面,其活性氧浓度在0.5~50 µmol/L[31];慢性炎症组织中的活性氧浓度最高可达500 µmol/L[32]。本研究用250 µmol/L的过氧化氢来模拟创面微环境,观察到PVA-TSPBA微针可以在过氧化氢中缓慢降解,于浸泡10 d完全溶解。金黄色葡萄球菌与大肠埃希菌分别是典型的革兰阳性菌和革兰阴性菌。在体外抗菌实验中,本课题组观察到对于金黄色葡萄球菌,含5.0 g/L ε-PL的PVA-ε-PL-TSPBA微针即可发挥良好的抗菌作用,而对于大肠埃希菌,含10.0 g/L ε-PL的PVA-ε-PL-TSPBA才有较好的抗菌效果,这可能是由于当抗菌药物浓度较低时,革兰阴性菌的外膜和LPS干扰了ε-PL与细菌的有效结合[33]。在随后的细胞毒性实验中,本课题组将3T3细胞与含0、1.0、5.0、10.0 g/L ε-PL的PVA-ε-PL-TSPBA微针共培养24 h后观察到,细胞活性及细胞形态均没有明显改变。由此可见,含有ε-PL的活性氧响应性微针不但可以有效响应活性氧发挥抗菌作用,还无明显细胞毒性。
透明质酸是一种广泛分布于结缔组织ECM中的生物活性大分子,具有良好的生物相容性,能够促进组织重塑、胶原沉积等[34, 35, 36, 37, 38, 39, 40]。SH是透明质酸的钠盐形式,与透明质酸的物理化学性质几乎相同,且具有良好的生物降解性。因此,为了提高活性氧响应性抗菌微针的力学性能,本研究在制备过程的最后一步加入了SH。实验结果显示,加有SH的PVA-TSPBA-SH微针的针体饱满,形态良好,微针的力学性能较PVA-TSPBA微针得到了约20倍的提高。进一步将PVA-TSPBA-SH微针按压在小鼠皮肤上1 min后,在皮肤上看到了明显的针孔,可见所制备的微针拥有足够的硬度能很好地刺入皮肤,从而有效提高药物的渗透性。通过体外细胞增殖实验观察到,PVA-ε-PL-TSPBA-SH微针对细胞的增殖有一定的促进作用。
目前关于糖尿病小鼠的造模方法以及小鼠皮肤感染创面模型的建立还没有一个明确的规范。本课题组诱导小鼠糖尿病模型后建立背部全层皮肤缺损创面,随后滴加金黄色葡萄球菌溶液来模拟糖尿病小鼠细菌定植全层皮肤缺损创面模型,并分别利用PVA-TSPBA-SH微针和含5.0 g/L ε-PL的PVA-ε-PL-TSPBA-SH微针进行治疗。结果观察到微针治疗组小鼠伤后各时间点创面愈合率较无菌敷贴组提高;伤后12 d,无菌敷贴组小鼠创面大部分未愈合,0 g/L ε-PL+SH组小鼠创面少许未愈合,5.0 g/L ε-PL+SH组小鼠的创面几乎完全愈合。本课题组还观察到,在创面愈合过程中,5.0 g/L ε-PL+SH组小鼠的创面干燥,没有明显的脓性渗出,这与伤后12 d小鼠创面组织学观察结果相一致:与另外2组相比,5.0 g/L ε-PL+SH组小鼠皮肤组织几乎完全愈合且炎症细胞浸润相对较少。这可能与抗菌微针在响应创面微环境中的活性氧后释放ε-PL抑制了细菌的增殖,从而减轻了创面的炎症反应有关。
综上,本研究制备了一种具有活性氧响应性且力学性能良好的抗菌微针,该微针可顺利刺穿皮肤并缓慢响应创面微环境中的活性氧从而溶解释放抗菌药物以促进创面修复。这种微针有望作为一种新型活性氧清除及抗菌材料,为糖尿病致慢性创面的治疗提供一种新的方案。然而,由于目前还没有一个公认的糖尿病小鼠造模规范,STZ诱导的糖尿病模型可能与自发糖尿病模型存在一定的差异,本课题组将在日后对此进行进一步研究与探索。
所有作者均声明不存在利益冲突